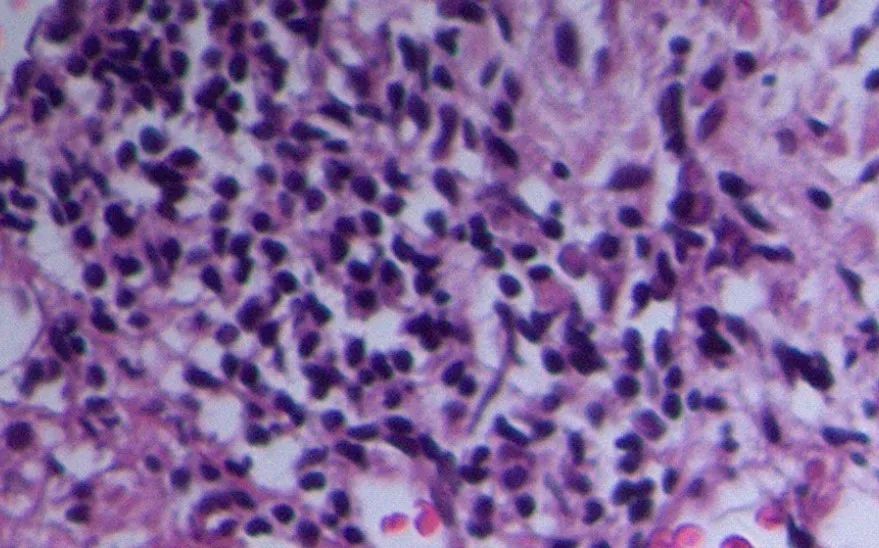
alp和ggt偏高是什么意思,alp和ggt下降意味着什么

作者:谭友文 江苏大学附属镇江三院
本文为作者授权医脉通发布,未经授权请勿转载。
对肝科医生来说,碱性磷酸酶(ALP)与γ-谷氨酰转肽酶(GGT)的异常升高,多会联想到最常见的胆管系统疾病,包括肝内胆汁淤积性疾病和肝外胆汁淤积性疾病。究其病因,也会想到病毒性肝炎、药物性、自身免疫性、梗阻性和代谢性等原因。
不过,笔者最近遇到了一例病因似乎常见,却又极其罕见的ALP与GGT异常升高病例,在此分享给大家。
病例分享
女,51岁,2个月前自服中药(蛇六谷、半枝莲、龙葵、延胡索和七叶莲),服用1个月后患者出现乏力不适症状,遂自行停用中药。后觉症状仍不缓解。遂至当地医院就诊,查肝功能明显异常。遂至我院就诊,门诊拟“肝损待查”接收入院作进一步诊治。
实验室检查(XX市人民医院 2019-10-19):(1)TBiL 15.5 umol/L,DBiL 6.3umol/L,A/G=42.7/37.1,ALT 145.1U/L,AST 102U/L,ALP 1171.1U/L,GGT 1057.0 U/L,GL0 5.31 mmol/L。(2)糖类抗原72-4:0.761 U/ml,糖类抗原19-9:18.64 U/ml;(3)甲胎蛋白(AFP):1.66 ng/ml,癌胚抗原(CEA):1.92 ng/ml。
入院初步考虑“药物性肝损伤”可能,进一步完善检查。病毒性肝炎标志物呈阴性;抗线粒体抗体(AMA)、抗平滑肌抗体(SMA)、抗肝肾微粒体抗体测定(LKM)、抗可溶性肝抗原抗体(抗-SLA抗体)均呈阴性;IgG:17.85 g/L(16 g/L)↑,IgA:2.26 g/L,IgM:2.06 g/L,抗心磷脂总抗体(ACA):112.59 RU/ml(<12 RU/ml)↑,糖类抗125:43.79 U/ml、铁蛋白:710.4ng/mL;FibroScan:CAP 316dB/m,LSM 5.3kPa。

图1 患者腹部增强CT图像
增强CT显示(图1):肝内胆管轻度扩张,胆囊壁增厚,胆总管轻度扩张。
初步思考
患者肝功能异常,以ALP、GGT异常升高为主,而ALT、AST仅轻度异常,虽然TBIL和DBIL水平均未提示出现明显淤胆表现,但结合CT检查结果提示应高度怀疑胆管性疾病。
寻找病因:患者有明确药物使用史,需要考虑药物性肝损伤(DILI)的可能,但DILI为排他性诊断,不宜首先考虑。在自身免疫性疾病抗体中出现IgG升高(17.85 g/L)、ACA升高(112.59 RU/ml),不能排除自身免疫性肝病的可能。因此,需行肝穿刺病理检查确诊。
初步肝组织病理解读

图2 肝组织病理:可见脂肪变性广泛存在
如图2,约40%的肝组织存在细胞脂肪变性,汇管区及小叶多基本正常,无明显的界面炎及小叶炎表现。
图3 肝组织病理:个别汇管区存在局灶纤维组织增生
如图3,在个别汇管区存在局灶纤维组织增生,汇管区小胆管增生,胆管周围淋巴细胞、浆细胞、中性粒细胞等混合性炎症细胞浸润。
如果病理解读到这里,对临床医生、病理医生和病人来说,给个“自身免疫性肝病”的诊断——如自身免疫性肝炎(AIH)或AMA阴性原发性胆汁性胆管炎(PBC)——都是可以接受的,予激素或者熊去氧胆酸(UDCA)治疗也应该没有错。
真的是自身免疫性肝病吗?
病理再读

图4 患者的病理切片(注意箭头所指)
看看图4,血管里,这是什么?

图5 患者的病理切片(注意红箭头和蓝箭头所指)
如图5,多个血管里出现异常组织(红箭头),并且有非常明显的有丝分裂,核异性(蓝箭头)。这不是肿瘤细胞吗?
最终诊断
问及病史,患者2年前曾确诊为卵巢癌(具体不详),化疗4次。
因此,我们考虑“卵巢癌肝转移”。
卵巢癌肝转移相关知识
卵巢位于盆腔深部,一旦发生肿瘤,在初期很少有症状出现,易延误早期诊断,以致确诊时60%-70%的卵巢癌患者已有卵巢外的肿瘤种植转移。生殖系统恶性肿瘤虽然可侵入胃肠道后由门静脉转移至肝脏或直接侵润肝脏,但由于生殖系统的血液与淋巴液均经腔静脉回流,先经小循环,再分布到全身。因此,生殖系统的恶性肿瘤远处转移常先发生于肺,肺转移灶的癌细胞脱落进入体循环,经动脉血进入肝脏而形成肝转移灶,所以临床上肝转移远较肺转移少见,肝转移灶为二级以上转移灶。
卵巢癌肝肺等实质器官转移病例,国内仅见个案和小样本报道。肝转移发生率占所有上皮性卵巢癌的6.9%(40/583)。肝、肺或脑的转移常常是一个晚期事件,即使是在尸检中,肝或肺的转移仅见于15%的病例。
诊治体会
这是一例因“不明原因性肝病”而住院治疗的患者,现有的资料均提示很常见的自身免疫性肝病和药物性肝病等可能。CT、病理检查可以很好地给出一个足够有说服力的,如AIH或AMA阴性PBC的诊断。
但不见肿瘤而诊断肿瘤,不见癌而诊断癌,却需要莫大的勇气。
我们认为,出现的混合炎症细胞浸润现象显然与肿瘤细胞在脉管的大量形成有关。
患者的治疗方案
这例病人我们没有采用内科予激素或者UDCA等常见治疗手段,而是直接建议病人转肿瘤科行化疗方案。
参考文献:
[1] 周良珍,吴志全.妇科恶性肿瘤肝转移的治疗[J].中国临床医学.1999,6(1):28.
[2] [美]琳达·D·法瑞尔,等.肝脏病理学[M].沈中阳,等,译.天津出版社,2014.
谭友文
主任医师 博士
江苏大学硕士生导师
江苏大学附属镇江三院肝科主任

医脉通专栏作者